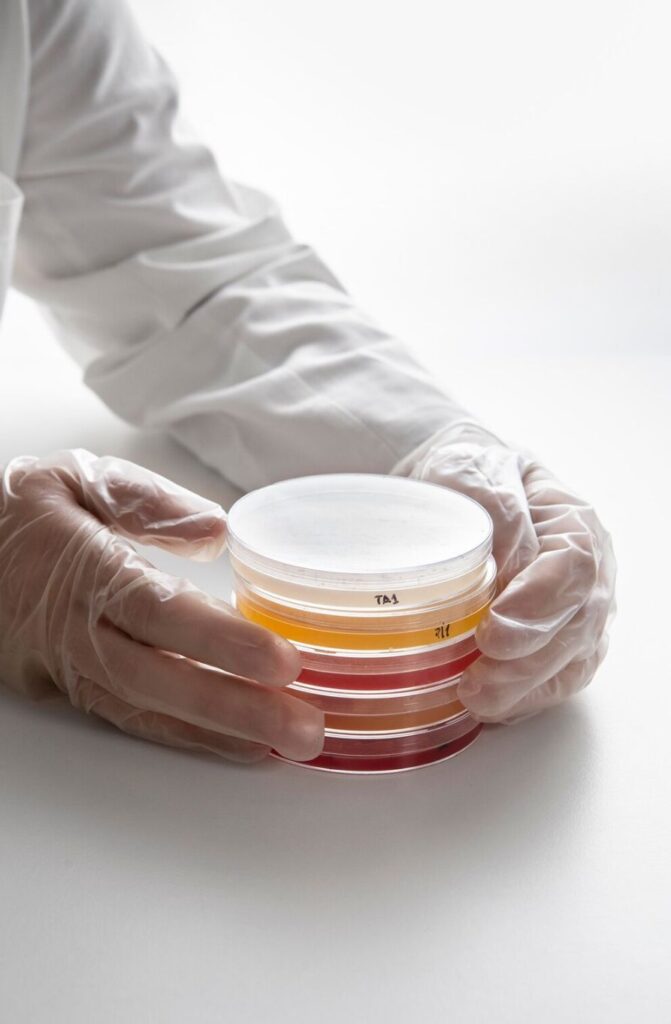
903

رؤيتنا
نرتقي معاً بالرعاية الصحية للجميع.
رسالتنا
تقديم نموذج مستدام ومبتكر للخدمات المخبرية يعزز دقة النتائج ويسهم في تحسين جودة الرعاية الصحية.

+
فروع منتشرة لخدمتك
K
مرضى تم خدمتهم
/7
خدمة عملاء مستمرة
+
تحليل وفحص مختلف

افضل الباقات الشاملة
الباقة الفضية
باقة شاملة تضم 21 تحليل تغطي صحة الدم، الكبد، الكلى، الغدة الدرقية، الدهون، المعادن والفيتامينات، بالإضافة إلى فحص السكر.
الباقة الذهبية
باقة شاملة لفحص 33 تحليل تغطي صحة الدم، الكبد، الكلى، الغدة الدرقية، الدهون، المعادن والفيتامينات، بالإضافة إلى فحوص السكر والالتهابات، لتقييم الحالة الصحية العامة والكشف المبكر عن أي خلل في الجسم.
الباقة الألماسية
باقة شاملة تضم 41 تحليل تشمل فحوص القلب والعضلات، وظائف الكبد والكلى، فقر الدم، الغدة الدرقية، السكر، الدهون، المعادن والفيتامينات، مع تحاليل إضافية للجهاز الهضمي والالتهابات، لتقديم صورة دقيقة وشاملة عن الصحة العامة.



